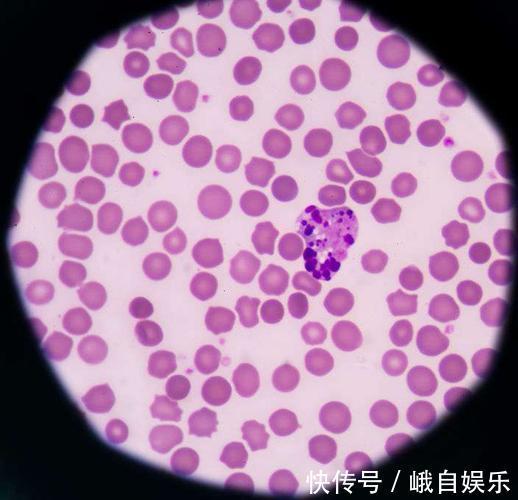
前列腺癌|癌症并非等于绝症,有4种癌就算到了晚期,也有治愈的可能

前列腺癌|癌症并非等于绝症,有4种癌就算到了晚期,也有治愈的可能
患者:医生,我到底还能活多久,是不是马上就要死了?
医生:不要太担心,你这种病情和癌症类型,很可能长期生存!
虽说医生给出了这样的答案,但是对部分癌症患者而言,癌症就等同于绝症。
即便是健康人群,也都错误地认为,癌症治不好、它除了会浪费钱之外,根本就没有什么治愈希望。
所以,有很多癌症患者还没有被癌本身打败,就被这错误的观念击垮了!

文章插图
但事实上,癌症≠绝症,在临床看来它就是一种恶性的慢性病而已!
根据权威的医疗杂志《柳叶刀》发布的文章内容来看,部分癌症患者5年内生存率已经超过了80%。
这项研究来自于我国17个癌症登记处,经过12年的跟踪随访,覆盖患者达到了2300万人。研究表明,各种癌症5年内生存率都有不同的增长;

文章插图
就连我国最为高发、死亡率相当高的肺癌,生存率也有了2%的涨幅。
这其中,最为客观的数据就是甲状腺分化癌,患者10年内的生存率都在80%左右,这让我们看到了新的希望!
而且,早在2006年,世卫组织就曾宣布:癌症就是一种可以预防、调控的慢性病!

文章插图
随着医疗水平不断进步,越来越多的癌症治疗办法问世,很多权威组织都已经将癌症从不治之症的范畴内剥离。
就目前而言,手术治疗、放化疗、免疫和靶向药物,都在癌症治疗上取得了不错的成果。比如以下四类癌症患者,完全没必要过度灰心:

文章插图
1、甲状腺分化癌:上文中已经提到了,甲状腺癌的临床治愈率非常高,它也被称为“最幸福的癌变”。
在我国全部的甲状腺癌患者中,有超过90%以上都属于甲状腺乳头状癌,它的恶性程度相当之低、进展速度非常缓慢、侵犯性较低,甚至是在患者病发后的几年内,肿瘤增长都可能会停滞不前。
所以,甲状腺癌及时治疗,预后效果相当好,它是所有实体恶性肿瘤中,生存率最高的类型,患者10年内总生存率都高达了80%以上;

文章插图
2、急性淋巴细胞白血病:白血病也被称为血癌,它在临床上有多个类型,急性淋巴细胞白血病就是较为高发的一种,其病发和遗传、病毒感染、电离辐射等多个因素都有关联,儿童、青少年就是该类疾病的高危人群。
数据调查显示,我国小儿急性淋巴细胞白血病患者,五年内生存率高到了90%以上,成年人5年之内的生存率也达到了80%左右;
文章插图
3、淋巴癌:淋巴遍布人体全身,它是人体内部仅次于血液循环的第二大循环系统。淋巴癌在我国的病发率并不高,其排名在8-10位左右,且在临床有不同的病理类型。
根据数据调查显示,如果患者能在早期接受正规治疗,70~80%左右的霍奇金淋巴瘤都可以痊愈。
而即便是较为多见的漫弥漫性b大细胞淋巴瘤,患者5年内生存率也达到了50%左右;

文章插图
4、前列腺癌:数据调查显示,在我国所有的前列腺癌患者中,超过80%以上都是65岁以上的男性,所以临床也认为它就是一种老年性疾病。
- 浴室里的“它”,可能是癌症帮凶,多数人洗澡时比较喜欢用
- 体内有癌,腰背先知晓?出现这2种标志,或是癌症“警告”?
- 清理血管|高血脂的“劲敌”被找到,并非山楂,若你爱吃,血脂或乖乖降下来
- 因为|糖尿病并非不许吃喝,饮食做到这5点,血糖不会差
- 补充|血糖的“抑制器”已找到,并非木耳,若你爱吃,血管或洁净如初
- 癌症|年仅四十出头却确诊癌症晚期,现在他只想说……
- 天然|15种能减少癌症发生的天然食物,日常多食用有助健康
- 小林|男子一晚呼吸暂停176次?睡觉打鼾并非好事,背后或与这3件事有关
- 医生|癌症是拖出来的,医生忠告,吃饭坚持三多三少,癌症才能更远
- 运动|为什么身体强壮的人会突然确诊癌症,体弱的却不会?快来了解一下
